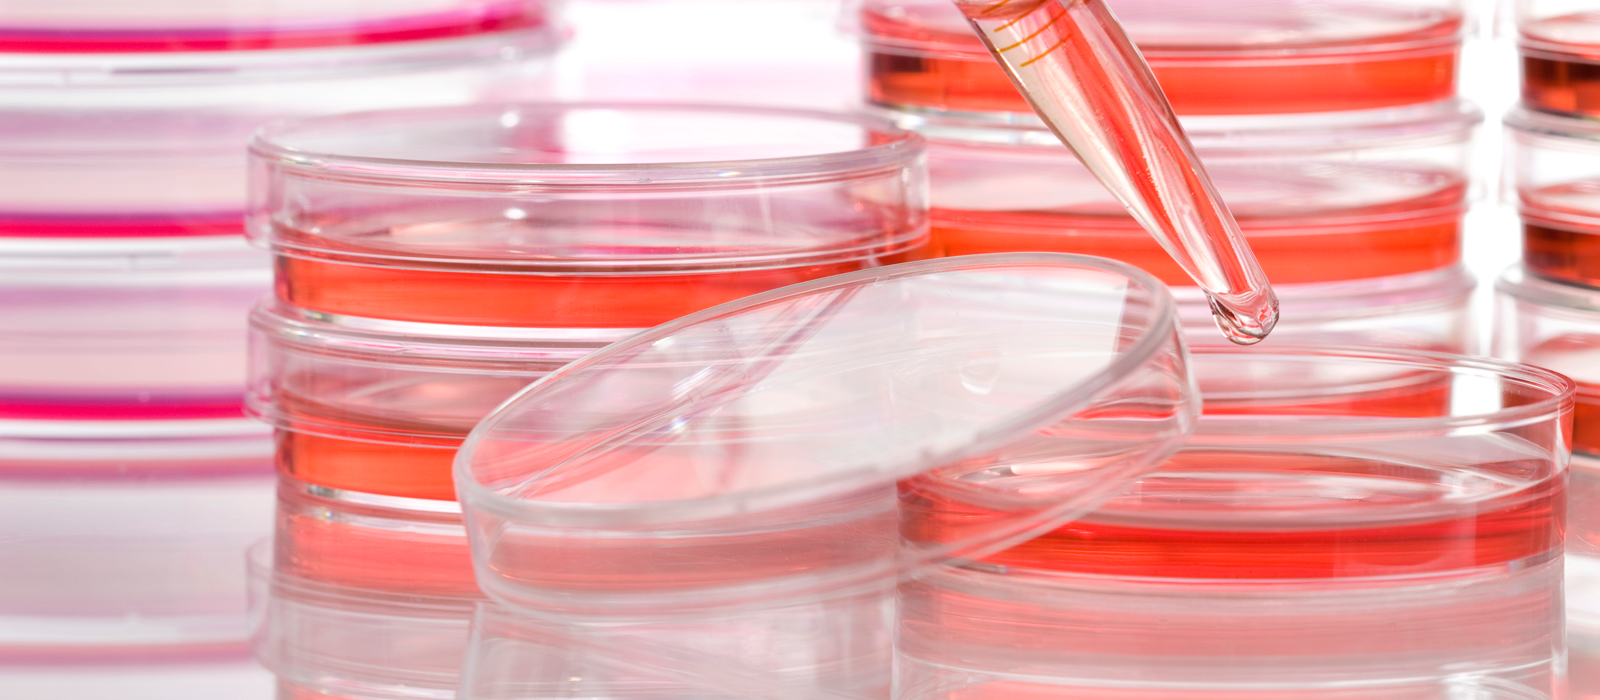

Microbiologia
A MICROBIOLOGIA é a ciência que estuda os micro-organismos, ou seja, organismos que só podem ser visualizados com a ajuda de equipamentos, como o microscópio. Estes micro-organismos podem ser eucariontes, cujo núcleo celular está envolto por uma membrana, como algas, fungos e protozoários; procariontes, nos quais o material genético está disperso no interior da célula, como as bactérias; ou acelulares (ou seja, sem célula), como vírus, viroides e prions.
O surgimento da MICROBIOLOGIA está diretamente ligado ao desenvolvimento tecnológico. Data de 1665 a primeira observação de micro-organismos, realizada pelo pesquisador inglês Robert Hooke, utilizando um microscópio que, apesar de rudimentar para os padrões atuais, representava importante avanço no século XVII. Outro nome de extrema importância para a área é o do cientista francês Louis Pasteur, cujas pesquisas possibilitaram descartar a teoria da geração espontânea, que dizia que a vida surgia de matéria inanimada, ao comprovarem a existência de organismos invisíveis a olho nu.
As pesquisas em MICROBIOLOGIA têm avançado bastante nos últimos anos. Estima-se que apenas um por cento de todas as espécies de micro-organismos do planeta tenham sido catalogadas. Embora estes sejam objeto de estudo há mais de três séculos, ainda há muito espaço para o desenvolvimento do campo da MICROBIOLOGIA se comparado com outras disciplinas da área de Ciências Biológicas. A rotina de estudos em MICROBIOLOGIA envolve principalmente pesquisas em laboratório e depende de aparelhos tecnológicos.
OBS: VOCÊ PRECISA ESTAR LOGADO NO GMAIL (OU EMAIL INSTITUCIONAL DA UEG) PARA ACESSAR OS LINKS, POIS TODOS OS LINKS SÃO VIA GOOGLE DOCS!